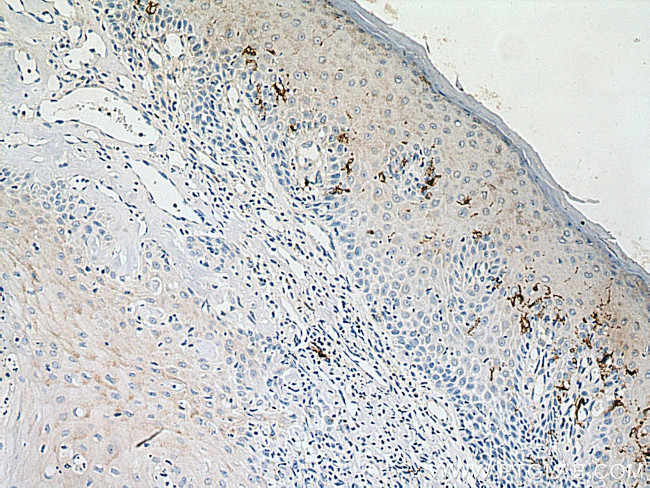
CD1a Antibody in Immunohistochemistry (Paraffin) (IHC (P))

Search
Proteintech
CD1a Polyclonal Antibody
{{$productOrderCtrl.translations['antibody.pdp.commerceCard.promotion.promotions']}}
{{$productOrderCtrl.translations['antibody.pdp.commerceCard.promotion.viewpromo']}}
{{$productOrderCtrl.translations['antibody.pdp.commerceCard.promotion.promocode']}}: {{promo.promoCode}} {{promo.promoTitle}} {{promo.promoDescription}}. {{$productOrderCtrl.translations['antibody.pdp.commerceCard.promotion.learnmore']}}
产品信息
17325-1-AP
种属反应
宿主/亚型
分类
类型
抗原
偶联物
形式
浓度
规格
纯化类型
保存液
内含物
保存条件
运输条件
产品详细信息
Immunogen sequence: MWNWLKEPL SFHVIWIASF YNHSWKQNLV SGWLSDLQTH TWDSNSSTIV FLWPWSRGNF SNEEWKELET LFRIRTIRSF EGIRRYAHEL QFEYPFEIQV TGGCELHSGK VSGSFLQLAY QGSDFVSFQN NSWLPYPVAG NMAKHFCKVL NQNQHENDIT HNLLSDTCPR FILGLLDAGK AHLQRQVKPE AWLSHGPSPG PGHLQLVCHV SGFYPKPVWV MWMRGEQEQQ GTQRGDILPS ADGTWYLRAT LEVAAGEAAD LSCRVKHSSL EGQDIVLYWE HHSSV (1-284 aa encoded by BC031645)
靶标信息
CD1a is a non-polymorphic MHC Class 1 related cell surface glycoprotein, expressed in association with Beta 2 microglobulin. CD1a is expressed by cortical thymocytes, Langerhan's cells and by interdigitating cells. CD1a is also expressed by some malignancies of T cell lineage and in histiocytosis X. CD1a is expressed on cortical thymocytes, epidermal Langerhans cells, dendritic cells, on certain T-cell leukemias, and in various other tissues. CD1a is structurally related to the major histocompatibility complex (MHC) proteins and form heterodimers with beta-2-microglobulin. The CD1 proteins mediate the presentation of primarily lipid and glycolipid antigens of self or microbial origin to T cells. The human genome contains five CD1 family genes organized in a cluster on chromosome 1. The CD1 family members are thought to differ in their cellular localization and specificity for particular lipid ligands. CD1a localizes to the plasma membrane and recycles vesicles of the early endocytic system. At least five CD1 genes (CD1a, b, c, d, and e) are identified. Alternatively spliced transcript variants of CD1a have been observed, but their biological validity have not been determined.
仅用于科研。不用于诊断过程。未经明确授权不得转售。
生物信息学
蛋白别名: CD1a; CD1a antigen precursor; CD1A antigen, a polypeptide; cluster of differentiation 1 A; cortical thymocyte antigen CD1A; differentiation antigen CD1-alpha-3; epidermal dendritic cell marker CD1a; hTa1 thymocyte antigen; T-cell surface antigen T6/Leu-6; T-cell surface glycoprotein CD1a; unnamed protein product
基因别名: CD1; CD1A; FCB6; HTA1; R4; T6
UniProt ID: (Human) P06126
Entrez Gene ID: (Human) 909